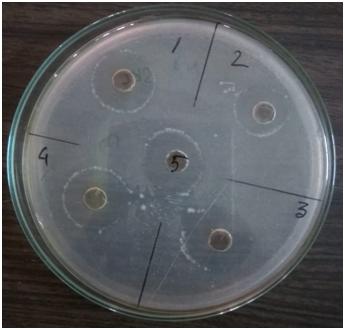

A medicinal plant is any plant that contains compounds that can be utilized for therapeutic purposes or that serves as a precursor for the creation of important pharmaceuticals. Normally, scientific researchers are responsible of assessing the benefit of plant families. Local people, on the other hand, are best qualified to determine the usefulness of specific plant species for a given application because they can draw on empirical knowledge gathered over a period of time [1]. Over millions of years, they have changed and adapted to fend off bacteria, insects, fungi, and the environment to create distinctive secondary metabolites with a variety of structural characteristics. Their ethno pharmacological properties have been used as a primary source of medicines for early drug discovery [2]. According to the World Health Organization (WHO), 80% of people still rely on plant based traditional medicines for primary health care (Farnsworth et al., 1985) and 80% of the plant derived drugs were related to their original ethno pharmacological purpose [3]. People have looked for natural remedies for their illnesses since ancient times. As is the case with animals, the first uses of medicinal plants were instinctual. Natural products have been used since ancient times and in folklore for the treatment of many diseases and illnesses [4]. They have been the source of most of the active ingredients of medicines. This is widely accepted to be true when applied to drug discovery in ‘olden times’ before the advent of high through screening and the post genomicera [5]. In truth, everything depended on practice because there wasn't enough information available at the time about the causes of the ailments or the best plant to use as a preventive medicine. As specific medicinal plants for treating particular ailments came to light over antiquity, the empirical base for their use grew and they started to be used as explanatory evidence. Up until the invention of medical science in the 16th century, prevention and therapy were provided by plants (Sofowora 2013)[6]. Since 5000 BC, medicinal herbs have been used in India as part of the Ayurvedic medical system. For the purpose of preventing and treating disease, this approach comprises dietary guidelines and herbal medicines that are tailored to the body, mind, and spirit [7]. According to reports, herbal medicines and their active ingredients can effectively heal human diseases and disorders while also having positive impacts on long term fitness. [3]. Since the beginning of time, people have researched using herbal remedies to treat a variety of illnesses and relieve pain. In addition to the aforementioned, the usage of medicinal plants dates back 60,000 years, when a Sumerian clay slab, a sort of equipment, was unearthed and used to verify the use of medicinal plants in the production of medications. Today, more than 50% of medications are natural and have some connection to plants in their origin. [3] Currently, both developed and developing nations frequently employ herbal medications for healthcare. Herbal medications are regarded as mixes of chemical substances produced by plants, and their effectiveness is constrained due to poor oral absorption. In the current situation, it becomes vital to standardise herbal goods and evaluate medicine quality in order to determine the quantity of their active constituents. The first record of using medicinal plants to make medications dates back to roughly 5000 years ago and was discovered on a Sumerian slab of clay from Nagpur. It contains 12 drug synthesis formulas that allude to more than 250 different plants, some of which contain alkaloids including mandrake, poppy, and henbane [3] . Proof from the Old Testament and the most sacred Jewish scripture called the Talmud showed that aromatic herbs like myrtle and incense were used during numerous rites following a treatment. [3] Many of the drugs that are currently on the market have either been directly or indirectly produced from plants, which have historically been an excellent source of pharmaceuticals. According to ethnobotanical data, 800 plants may have anti-diabetic properties (Alarcon-Aguilara et al., 1998) [8]. When tested using currently available experimental procedures, a number of these herbs have demonstrated anti-diabetic action. According to Bailey and Day (1989), Ivorra et al. (1988), Marles and Farnsworth (1995), a variety of active principles derived from plants that represent a variety of chemical compounds have shown activity commensurate with their potential application for the therapeutic use of Non-Insulin-Dependent-Diabetes. [9]. They play a key role in offering basic healthcare to people who live in rural areas. They are also used as essential components for the production of both conventional and modern medications as well as therapeutic agents. Tropical rainforests in central and south America are home to the perennial evergreen shrub Sanchezia nobilis (Acanthaceae) [10]. Plants in the Sanchezia genus can be utilised as anti-tuberculosis, anti-tumor, anticonvulsants, cough sedatives, and expectorants in traditional medicine [11].The world's greatest diversity of plant species can be found in tropical regions, some of which may have therapeutic benefits. During the course of this investigation, Sanchezia nobilis, a tropical plant, was examined for its leaves. The lowland regions of tropical Central and South America are home to members of this genus, which are shrubs, small trees, and occasionally plants. The three species S. nobilis, S. parvibracteata, and S. speciosa are examples of well-known species [12]. Some species have become recognised for their therapeutic properties and are frequently utilised, but it is unknown whether the majority of plants in tropical forests contain active ingredients [13]. As a result, comprehensive scientific screening is needed to assess these plants. Therefore, the goal of this research effort was to look for bioactive substances and assess the pharmacological effects of this plant's leaves. According to studies, these substances have anti-inflammatory, anti-bacterial, anti-fungal, anti-cancer, and antioxidant activities. There haven't been many investigations into Sanchezia speciosa's pharmacological properties and chemical composition. Therefore, there is no exhaustive identification of the basic chemical constituents and comprehensive quality control of this genus. S. speciosa contains cardiac and flavonoid glycosides and their extracts exhibit antioxidant and anti-inflammatory activities [14]. Extracts of the same species exerted cytotoxicity in human epithelial cervical cancer cell lines[14]. Sanchezia oblonga Ruiz & Pav. (syn. Sanchezia nobilis Hook. f.) is a perennial evergreen shrub from the rainforests of Central and South America [15]. An previous study discovered that S. nobilis extracts include syringin, flavone glycosides, cinnamyl and benzyl alcohol glycosides, and neolignan glucoside in addition to the matsutake alcohol glycosides. When necessary, the bioactive ingredient is then extracted, fractionated, and isolated. In addition, it comprises determination of quantity and quality of bioactive compounds. Efficacy and ease of administration are among the reasons that plants are becoming increasingly popular as source of medicine, especially since they are natural, are available in local communities, and are cheaper to buy. Furthermore, herbal medicine may be a substitute to conventional medicine in cases where a drug’s side effects are severe and drug resistance exists. When extracting medicinal plants, active substances such alkaloids, flavonoids, terpenes, saponins, steroids, and glycosides are separated from inert or inactive material using a suitable solvent and accepted extraction techniques. Plant products with high levels of phenolic and flavonoid chemicals have been shown to have antioxidant characteristics and are therefore utilised to treat age-related illnesses like Alzheimer's disease, Parkinsonism, anxiety, and depression [16]. The process of obtaining medicinal plants was carried out in a variety of ways such as maceration, infusion, decoction, percolation, digestion and Soxhlet extraction, superficial extraction, ultrasound-assisted, and microwave-assisted extraction [17]. In addition, thin-layer chromatography (TLC), high-performance liquid chromatography (HPLC), paper chromatography (PC), and gas chromatography (GC) were used in purification and separation of the secondary metabolites. When choosing an extraction technique, solvent to be employed, solvent pH, temperature, and solvent to sample ratio, it is crucial to take the nature of the plant material into account. It also relies on how the finished products are going to be used. The objective of this study was to evaluate various extraction solvents, procedures, fractionation, and purification techniques as well as phytochemical screening and identification of bioactive chemicals in Sanchezia oblongamedicinal plants.


 Swapan Kumar Chowdhury*
Swapan Kumar Chowdhury*
 Tanmoy Mazumdar
Tanmoy Mazumdar

10.5281/zenodo.17060288
10.5281/zenodo.17060288